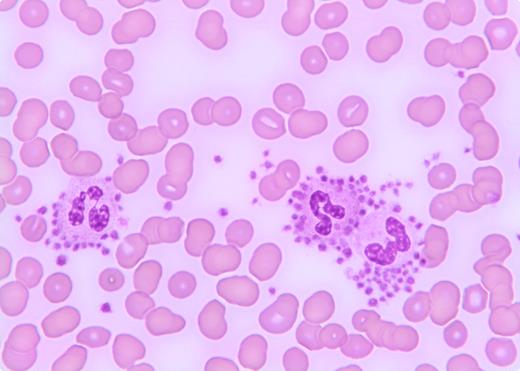
A 72-year-old male with a history of increasing dyspnea and weight loss underwent a chest X-ray that revealed a pulmonary mass and thus he was seen by pulmonary service for bronchoscopy. However, routine blood count showed a platelet count of 35 × 109/L with a normal hemoglobin and white blood cell count. He was referred to hematology for evaluation of thrombocytopenia. Physical examination was unremarkable. A repeat platelet count was 32 × 109/L. Review of the peripheral smear disclosed numerous platelets surrounding the granulocytes consistent with platelet satellitism (see figure) causing pseudothrombocytopenia. He underwent bronchoscopy without complications. / Spurious thrombocytopenia is a problem in clinical practice that may sometimes lead to unnecessary evaluations and treatment. Platelet satellitism, which is an in vitro phenomenon, is associated with EDTA-treated blood at room temperature. It is seen in patients with vasculitis, lupus, mantle cell lymphoma, and marginal zone B-cell lymphoma, and most commonly in healthy individuals. One of the proposed mechanisms is IgG autoantibodies directed against platelet glycoprotein IIb/IIIA complex and the neutrophil Fc γ receptor III. Astute clinicians should be familiar with this spurious cause of thrombocytopenia and should review the peripheral blood smear in all patients with thrombocytopenia.

A 72-year-old male with a history of increasing dyspnea and weight loss underwent a chest X-ray that revealed a pulmonary mass and thus he was seen by pulmonary service for bronchoscopy. However, routine blood count showed a platelet count of 35 × 109/L with a normal hemoglobin and white blood cell count. He was referred to hematology for evaluation of thrombocytopenia. Physical examination was unremarkable. A repeat platelet count was 32 × 109/L. Review of the peripheral smear disclosed numerous platelets surrounding the granulocytes consistent with platelet satellitism (see figure) causing pseudothrombocytopenia. He underwent bronchoscopy without complications.
Spurious thrombocytopenia is a problem in clinical practice that may sometimes lead to unnecessary evaluations and treatment. Platelet satellitism, which is an in vitro phenomenon, is associated with EDTA-treated blood at room temperature. It is seen in patients with vasculitis, lupus, mantle cell lymphoma, and marginal zone B-cell lymphoma, and most commonly in healthy individuals. One of the proposed mechanisms is IgG autoantibodies directed against platelet glycoprotein IIb/IIIA complex and the neutrophil Fc γ receptor III. Astute clinicians should be familiar with this spurious cause of thrombocytopenia and should review the peripheral blood smear in all patients with thrombocytopenia.
A 72-year-old male with a history of increasing dyspnea and weight loss underwent a chest X-ray that revealed a pulmonary mass and thus he was seen by pulmonary service for bronchoscopy. However, routine blood count showed a platelet count of 35 × 109/L with a normal hemoglobin and white blood cell count. He was referred to hematology for evaluation of thrombocytopenia. Physical examination was unremarkable. A repeat platelet count was 32 × 109/L. Review of the peripheral smear disclosed numerous platelets surrounding the granulocytes consistent with platelet satellitism (see figure) causing pseudothrombocytopenia. He underwent bronchoscopy without complications.
Spurious thrombocytopenia is a problem in clinical practice that may sometimes lead to unnecessary evaluations and treatment. Platelet satellitism, which is an in vitro phenomenon, is associated with EDTA-treated blood at room temperature. It is seen in patients with vasculitis, lupus, mantle cell lymphoma, and marginal zone B-cell lymphoma, and most commonly in healthy individuals. One of the proposed mechanisms is IgG autoantibodies directed against platelet glycoprotein IIb/IIIA complex and the neutrophil Fc γ receptor III. Astute clinicians should be familiar with this spurious cause of thrombocytopenia and should review the peripheral blood smear in all patients with thrombocytopenia.
For additional images, visit the ASH IMAGE BANK, a reference and teaching tool that is continually updated with new atlas and case study images. For more information visit http://imagebank.hematology.org.